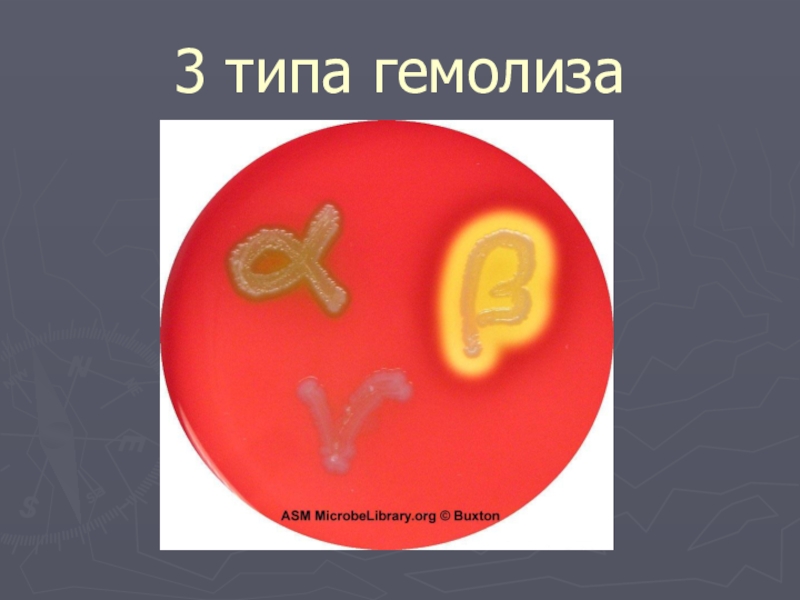
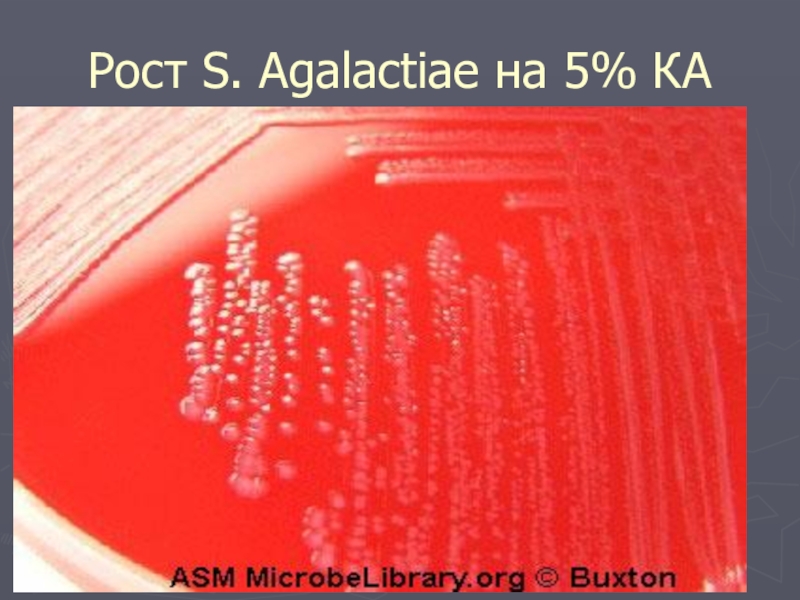
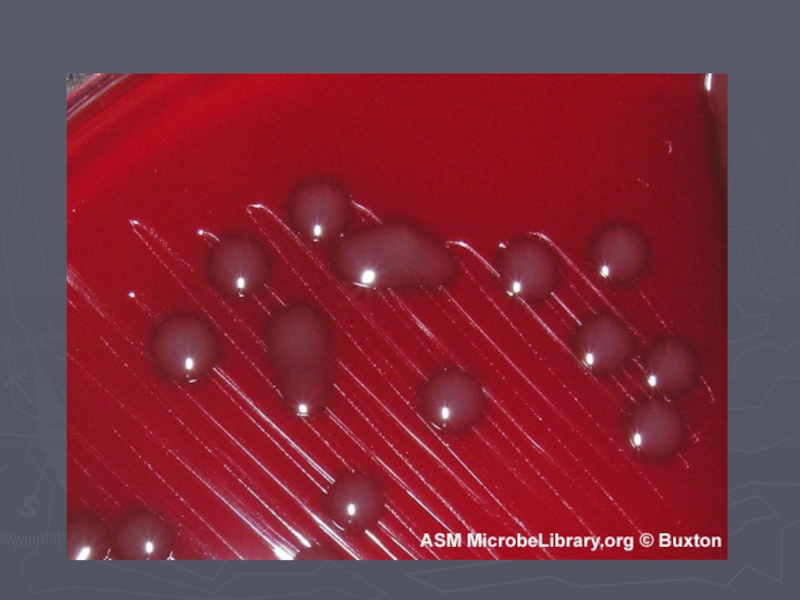
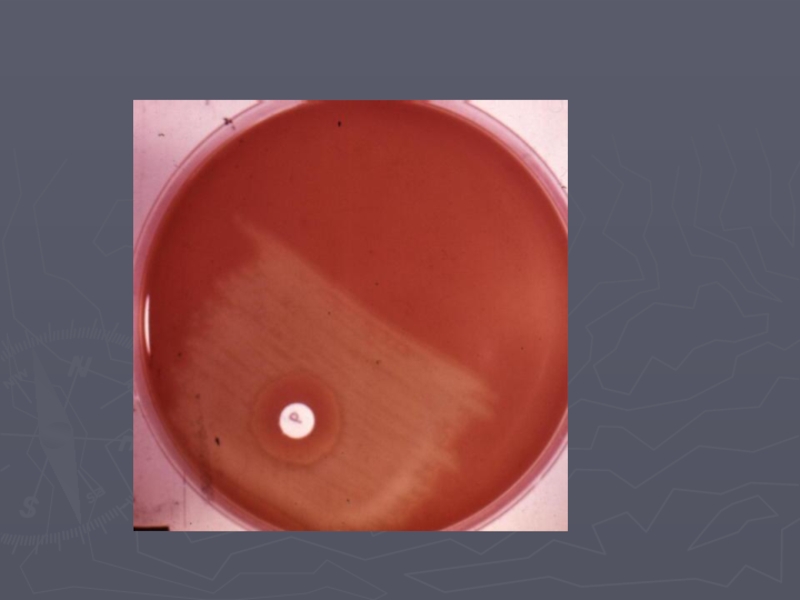

- Главная
- Разное
- Образование
- Спорт
- Естествознание
- Природоведение
- Религиоведение
- Французский язык
- Черчение
- Английский язык
- Астрономия
- Алгебра
- Биология
- География
- Геометрия
- Детские презентации
- Информатика
- История
- Литература
- Математика
- Музыка
- МХК
- Немецкий язык
- ОБЖ
- Обществознание
- Окружающий мир
- Педагогика
- Русский язык
- Технология
- Физика
- Философия
- Химия
- Шаблоны, фоны, картинки для презентаций
- Экология
- Экономика
Презентация, доклад по биологии Стрептококк
Содержание
- 1. Презентация по биологии Стрептококк
- 2. Стрептококки - Гр+, круглые или овальные микроорганизмы
- 3. Слайд 3
- 4. II группа Стрептококки ротовой полости (28 видов)
- 5. Большинство гемолитических стрептококков относятся к видам
- 6. Слайд 6
- 7. 2.Зеленящие стрептококки (Streptococcus viridans)Образуют зоны серо-зеленого или
- 8. 3.Негемолитические (гамма) - стрептококки Не продуцируют гемотоксинов
- 9. 3 типа гемолиза
- 10. Основные возбудители стрептококковых инфекций:S. pyogenes –
- 11. Основные заболевания, которые вызывает пиогенный стрептококк:Специфические:1. Стрептококковая
- 12. Стрептококковая ангина
- 13. 2. Скарлатина (scarlet - алый) – разновидность
- 14. Стрептодермия
- 15. 4. Рожистое воспаление – острое воспаление кожи
- 16. Рожистое воспаление лица
- 17. Кроме этого S. Pyogenes может вызывать гнойно-воспалительные заболевания любой локализации
- 18. Все эти инфекции могут осложниться: 1. ревматизмом
- 19. S. pyogenes
- 20. Слайд 20
- 21. S. Agalactiae вызывает патологию у новорожденных
- 22. У рожениц может вызвать эндометриты, циститы, пиелонефриты
- 23. S. Agalactiae
- 24. Рост S. Agalactiae на 5% КА
- 25. Чувствительность к АБ гемолитических стрептококков1. Бетта-лактамные АБ 2. Макролиды 3. Клиндамицин4. Ванкомицин, тейкопланин
- 26. S. pneumoniae
- 27. S. pneumoniae в мазке из материала
- 28. Слайд 28
- 29. Рост зеленящих стрептококков на КА
- 30. Реакция Нейфельда
- 31. Слайд 31
- 32. Благодарю за внимание!
Стрептококки - Гр+, круглые или овальные микроорганизмы размерами от 0,5 до 2,5 мкм в диаметре, образующие цепочки (streptos греч. - цепь)НеподвижныМогут иметь капсулуФакультативные анаэробы
Слайд 2Стрептококки - Гр+, круглые или овальные микроорганизмы размерами от 0,5 до
2,5 мкм в диаметре, образующие цепочки (streptos греч. - цепь)
Неподвижны
Могут иметь капсулу
Факультативные анаэробы
Неподвижны
Могут иметь капсулу
Факультативные анаэробы
Слайд 4II группа Стрептококки ротовой полости (28 видов)
Являются нормальными представителями
микрофлоры носоглотки человека
Однако к ним относится такой близкий к патогенным
вид, как
1. S. pneumoniae
Однако к ним относится такой близкий к патогенным
вид, как
1. S. pneumoniae
Слайд 5Большинство гемолитических стрептококков относятся к видам
S. pyogenes и S. аgalactiae
Бета-гемолиз
(расщепление крови) могут давать:
1. все пиогенные стрептококки
2. из оральных стрептококков - группа Аnginosus
3. энтерококки
1. все пиогенные стрептококки
2. из оральных стрептококков - группа Аnginosus
3. энтерококки
Слайд 72.Зеленящие стрептококки (Streptococcus viridans)
Образуют зоны серо-зеленого или коричневого цвета - альфа-гемолиз
Альфа-гемолиз
обусловлен неполным разрушением эритроцитов и превращением гемоглобина в метгемоглобин
К зеленящим относится большинство стрептококков ротовой полости и S.bovis
К зеленящим относится большинство стрептококков ротовой полости и S.bovis
Слайд 83.Негемолитические (гамма) - стрептококки
Не продуцируют гемотоксинов и в основном не
имеют значения в патологии
Среди видов, которые могут вызывать патологию и не дают гемолиза основные S. мutans и S. sanguinis
Среди видов, которые могут вызывать патологию и не дают гемолиза основные S. мutans и S. sanguinis
Слайд 10Основные возбудители стрептококковых инфекций:
S. pyogenes – гемолитический, группа А
S. agalactiae
– гемолитический, группа В
S. pneumoniae – зеленящий
S. pneumoniae – зеленящий
Слайд 11Основные заболевания, которые вызывает пиогенный стрептококк:
Специфические:
1. Стрептококковая ангина - острое воспаление
зева и миндалин (angere - сжимать)
Болеют дети, реже взрослые
Болеют дети, реже взрослые
Слайд 132. Скарлатина (scarlet - алый) – разновидность ангины с алой мелкой
сыпью и сильной интоксикацией (дети)
3. Стрептококковая пиодермия - очень контагиозная, может протекать по типу вспышек. Возникает чаще летом, способствует жаркий влажный климат. Болеют дети.
3. Стрептококковая пиодермия - очень контагиозная, может протекать по типу вспышек. Возникает чаще летом, способствует жаркий влажный климат. Болеют дети.
Слайд 154. Рожистое воспаление – острое воспаление кожи нижних конечностей, головы и
лица. Сопровождается отеком и лимфостазом. Поражаются в основном взрослые (спорадические случаи)
Слайд 18Все эти инфекции могут осложниться:
1. ревматизмом - аутоиммунное поражение суставов
и оболочек сердца
2. гломерулонефритом - тяжелое аутоиммунное поражение почек
2. гломерулонефритом - тяжелое аутоиммунное поражение почек
Слайд 22У рожениц может вызвать эндометриты, циститы, пиелонефриты и нагноение раны после
Кесарева сечения
Кроме этого очень редко S. agalactiae может вызывать пневмонию (особенно после вирусных респираторных инфекций), менингит и сепсис у взрослых
Кроме этого очень редко S. agalactiae может вызывать пневмонию (особенно после вирусных респираторных инфекций), менингит и сепсис у взрослых
Слайд 25Чувствительность к АБ гемолитических стрептококков
1. Бетта-лактамные АБ
2. Макролиды
3. Клиндамицин
4.
Ванкомицин, тейкопланин